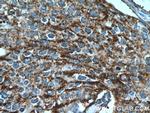
POLD3 Antibody in Immunohistochemistry (Paraffin) (IHC (P))
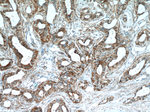
POLD3 Antibody in Immunohistochemistry (Paraffin) (IHC (P))

Search
Proteintech
POLD3 Polyclonal Antibody
{{$productOrderCtrl.translations['antibody.pdp.commerceCard.promotion.promotions']}}
{{$productOrderCtrl.translations['antibody.pdp.commerceCard.promotion.viewpromo']}}
{{$productOrderCtrl.translations['antibody.pdp.commerceCard.promotion.promocode']}}: {{promo.promoCode}} {{promo.promoTitle}} {{promo.promoDescription}}. {{$productOrderCtrl.translations['antibody.pdp.commerceCard.promotion.learnmore']}}
产品信息
21935-1-AP
种属反应
宿主/亚型
分类
类型
抗原
偶联物
形式
浓度
规格
纯化类型
保存液
内含物
保存条件
运输条件
产品详细信息
Immunogen sequence: MLKDSGPLF NTDYDILKSN LQNCSKFSAI QCAAAVPRAP AESSSSSKKF EQSHLHMSSE TQANNELTTN GHGPPASKQV SQQPKGIMGM FASKAAAKTQ ETNKETKTEA KEVTNASAAG NKAPGKGNMM SNFFGKAAMN KFKVNLDSEQ AVKEEKIVEQ PTVSVTEPKL ATPAGLKKSS KKAEPVKVLQ KEKKRGKRVA LSDDETKETE NMRKKRRRIK LPESDSSEDE VFPDSPGAYE AESPSPPPPP SPPLEPVPKT EPEPPSVKSS SGENKRKRKR VLKSKTYLDG EGCIVTEKVY ESESCTDSEE ELNMKTSSVH RPPAMTVKKE PREERKGPKK GTAALGKANR QVSITGFFQR K (107-466 aa encoded by BC108908)
靶标信息
DNA replication, recombination and repair, all of which are necessary for genomic stability, require the presence of exonucleases. In DNA replication, exonucleases are involved in the processing of Okazaki fragments, whereas in DNA repair, they function to excise damaged DNA fragments and correct recombinational mismatches. These exonucleases include the family of DNA polymerases, namely DNA pol alpha, beta, delta and epsilon. DNA pol delta and DNA pol epsilon are multisubunit enzymes, with DNA pol delta consisting of two subunits which interact with the sliding DNA clamp protein PCNA. DNA pol delta 3, also known as POLD3 or p66, is a 466 amino acid nuclear protein that is required for the proper function of DNA pol delta.
仅用于科研。不用于诊断过程。未经明确授权不得转售。
生物信息学
蛋白别名: DNA pol delta3; DNA polymerase delta subunit 3; DNA polymerase delta subunit C; DNA polymerase delta subunit p66; DNA polymerase delta subunit p68; DNA-directed DNA polymerase delta 3; DNApol delta3; GC12; KIAA0039; Pol delta C subunit (p66); polymerase (DNA directed), delta 3; polymerase (DNA) delta 3, accessory subunit; polymerase (DNA-directed), delta 3, accessory subunit; protein phosphatase 1, regulatory subunit 128; unnamed protein product
基因别名: 2410142G14Rik; C85233; IMD122; KIAA0039; P66; P68; POLD3; PPP1R128
UniProt ID: (Human) Q15054, (Mouse) Q9EQ28
Entrez Gene ID: (Human) 10714, (Rat) 293144, (Mouse) 67967